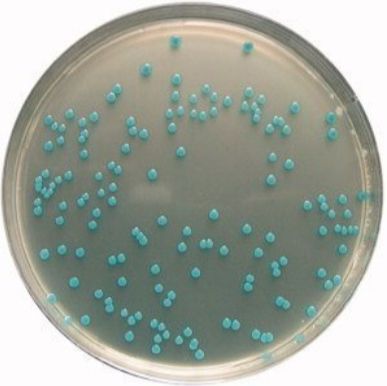
产品封面图

万千商家帮你免费找货
0 人在求购买到急需产品
- 详细信息
- 文献和实验
- 技术资料
- 库存:
68
- 英文名:
Lentinus lepideus Fries
- 保质期:
3年
- 供应商:
优利科(上海)生命科学有限公司
- 保存条件:
2-8℃
- 规格:
冻干粉
| 中文名称:洁丽香菇 豹皮菇 |
| 拉丁名称:Lentinus lepideus Fries |
| 来源历史: |
| 原始编号: |
| 原产国:中国 |
| 模式菌株: 否 |
| 主要用途:食用兼药用 |
| 生物安全级别: 一级 |
| 培养温度:25℃ |
| 培养时间:7-14d |
| 需氧类型:好氧 |
| 分离基物: |
| 采集地: |
| 保存方法: 斜面保藏 |

洁丽香菇 豹皮菇菌种冻存方法:
菌种保藏是指保持微生物菌株的活力和遗传性状的技术。微生物在使用和传代过程中容易发生污染、变异甚至死亡,因而常常造成菌种的衰退。菌种保藏的目的就是使菌株存活、不丢失、不污染杂菌、不发生或少发生变异,保持菌种原有的活性和各种特征。菌种保藏的基本原理是使微生物的生命活动处于半永久性的休眠状态,也就是将微生物的新陈代谢作用限制在最低范围内。

需氧培养:
大多数的细菌、霉菌、放线菌培养法均为需氧培养。
培养基接种微生物后放于35 ℃~37 ℃或25℃恒温培养箱(或水浴箱)中,培养18 h-24h或3d-5d,大多数菌能看到明显的菌落,可以进行计数及鉴定。需氧培养法按培养基的状态来分,可分为三类。
固体培养法是指将微生物接种在固体培养基上生长繁殖的方法,固体培养基包括琼脂平板和琼脂斜面。琼脂平板用于菌落计数和分离菌落和菌落形态观察,琼脂斜面用于保藏。
液体培养法是利用液体培养基对微生物进行培养的方法,用于菌种的选育及生化试验和发酵试验等。
利用半固体培养基进行培养的方法,半固体培养基含有一定的琼脂(0.02%-0.3% ),使培养基有一定的黏度,但没有完全固化。培养时,盛半固体培养基的试管放置于试管架上,然后置于培养箱中进行培养。一般用于生化试验,可用于判别微生物的运动性。
洁丽香菇 豹皮菇注意事项:
1、请务必了解培养微生物需要注意的安全事项,默认由微生物专业技术人员操作;
2、建议严格按照 培养说明来操作,认真阅读说明,尤其是要点提示部分,并记录好菌种编号和菌种制作日期(批号);
3、使用前,认真阅读并理解随货的“菌种培养说明”和“开管说明”如有任何疑问,请于操作前咨询我司。
4、如若有菌种复苏不活或污染等情况,请在收到菌种后1个月内联系我司,逾期将不予受理。


洁丽香菇 豹皮菇相关产品:
| 芽孢杆菌属 | Bacillus sp. | 冻干粉;斜面;菌液;平板 | |
| 胶质芽孢杆菌 | Bacillus mucilaginosus Krassilnikov | 冻干粉;斜面;平板 | |
| 巨大芽孢杆菌 | Bacillus megatherium de Bary | 冻干粉;斜面;菌液;平板 | |
| 地衣芽孢杆菌 | Bacillus licheniformis(Weigmann) Chesteremend.Gibson | 冻干粉;斜面;菌液;平板 | |
| 地衣芽孢杆菌 | Bacillus licheniformis (Weigmann) Chester emend. Gibson | 冻干粉;斜面;菌液;平板 | |
| 地衣形芽孢杆菌 | Bacillus licheniformis (Weigmann)Chesteremend.Gibson | 冻干粉;斜面;菌液;平板 | |
| 固氮菌 | Azotobacter sp. | 冻干粉;平板 | |
| 巴氏醋杆菌 | Acetobacter pasteurianus | 冻干粉;平板 | |
| 咽颊炎链球菌 | Streptococcus anginosus | 冻干粉;平板 | |
| 黄曲霉 | Aspergillus flavus Link | 冻干粉;斜面;菌液;平板 | |
| 表皮葡萄球菌(RP62A) | Staphylococcus epidermidis (Winslow and Winslow) Evans | 冻干粉;斜面;菌液;平板 | |
| 脑膜炎奈瑟菌 | Neisseria meningitidis (Albrecht and Ghon) Murray | 冻干粉;平板 | |
| 红平红球菌 | Rhodococcus erythropolis | 冻干粉;斜面;菌液;平板 | |
| SC-587 [CBS 549.77] | Talaromyces marneffei | 冻干粉;斜面;菌液;平板 | |
| 猪霍乱沙门氏菌猪霍乱亚种 | Salmonella enterica subsp. | 冻干粉;斜面;菌液;平板 | |
| 里氏木霉 | Trichoderma reesei Simmons | 冻干粉;斜面;菌液;平板 | |
| 热带假丝酵母 | Candida tropicalis (Castellani) Berkhout | 冻干粉;斜面;菌液;平板 | |
| 白假丝酵母 | Candida albicans (Robin) Berkhout | 冻干粉;斜面;菌液;平板 | |
| 肠炎沙门氏菌肠炎亚种鼠伤寒血清型 | Salmonella enterica subsp. enterica serovar Typhimurium | 冻干粉;斜面;菌液;平板 | |
| 副溶血性弧菌(嗜盐菌) | Vibrio parahaemolyticus (Fujino et al.) Sakazaki et al. | 冻干粉;斜面;菌液;平板 | |
| 大肠埃希氏菌 | Escherichia coli (Migula) Castellani and Chalmers | 冻干粉;斜面;菌液;平板 | |
| 酿酒酵母 | Saccharomyces cerevisiae Meyen ex E.C. Hansen, | 冻干粉;斜面;菌液;平板 |
风险提示:丁香通仅作为第三方平台,为商家信息发布提供平台空间。用户咨询产品时请注意保护个人信息及财产安全,合理判断,谨慎选购商品,商家和用户对交易行为负责。对于医疗器械类产品,请先查证核实企业经营资质和医疗器械产品注册证情况。
 文献和实验
文献和实验)。依出菇温度可分为高温型、中温型、低温型,三者出菇盛期的适宜温度分别为18-22℃,10-18℃及5-10℃。 生物学特性:菌盖半肉质,直径5-12cm,扁半球形,后渐平展,黄褐色至深肉桂色,上有鳞片。菌肉厚,白色,菌褶白色,稠密,弯生。柄中生至偏生,白色,内实,常弯曲,长3-5cm,直径0.5-0.8cm,菌环以下部分往往覆有鳞片。菌环窄而易消失。孢子无色,光滑。椭圆形,5×2.5μ。 香菇为异宗结合的四极性菌类。一个子实体能产生4种不同交配型(A1B1、A2B2、A1
菌丝洁白、粗壮、舒展、均匀,边缘整齐,生长速度快;在瓶壁呈扇面羽毛状发展,生长健壮,会分泌酱油色的水珠。菌丝长满瓶后,10~15天内常见到琥珀色透明液体,并具有香菇特有的芳香气味,无臭味和霉味。 如瓶内菌丝柱与瓶壁脱离,说明培养料水分过多所致;若既脱离,菌丝柱又开始萎缩,表面菌皮增厚并变为深褐色,说明菌种已开始老化,不能久存,应立即使用。 若菌种柱表面已出现小菇蕾,是好菌种的特征之一,应去掉菇蕾尽快使用;若出现大量菇蕾,则说明菌龄较大已老化,不宜使用
真菌门、担子菌纲、口蘑科、香菇属。子实体伞状,半肉质至革质。菌盖扁平球形,后渐平展,宽 5~ 12厘米,菱色至深肉桂色,上有鳞片。菌肉厚,白色。菌褶白色,稠密,弯生。柄中生至偏生,白色,内实,常弯曲,长 3~ 5厘米,粗 0.5~ 0.8厘米,有窄的菌环,易消失。菌环以下的菌柄上常有鳞片。担孢子无色,光滑,椭圆形。常生于阔叶树的倒木上。我国长江以南各省区均有分布。香菇味美而营养丰富,每 100克干菇中含 12.5克蛋白质,糖 60克,脂肪为 6.4克,还有多量的麦角固醇和维生